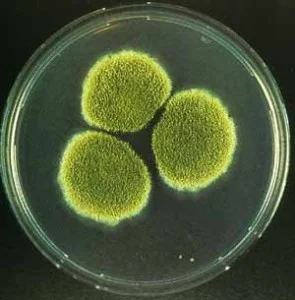
Antibiotics: Friend or Foe?

After thirty years as an herbalist I had become a bit jaded about “new” herbal discoveries. Until one appeared on my shelf that really opened my eyes!
Read MoreAs far back as 1994 medical research realized that there were specific illnesses caused by organisms that had unique abilities. They were able to not just “infect” you, they could adapt to your immune system and evade your body’s attempts to resolve them. These became known as stealth pathogens and it meant that they could live in your body for very long periods of time.
Read MoreBy now you’re wondering what this has to do with health? Listening to people say that flowers and gardens aren’t worth the time, effort and cost sounds very much like the person who says they don’t want to take vitamins every day, don’t have the time to take a walk, can’t be bothered cooking for themselves. They avoid the necessity of tending to their health in favor of a maintenance-free lifestyle. Our health is now determined by how we choose to spend our time and our effort – tending our gardens or simply mowing the lawn.
Read MoreThat famous phrase was not just the philosophy of the Borg, it is a continual struggle in conventional medicine. Bugs are smart and the more we use a drug to treat an infection, the more adapted to the drug and therefore the more resistant a bug becomes. But natural medicine uses a different approach.
Read MoreWhen you enter the world of natural medicine, you have to be prepared to take pills. Organic, natural, healthy, but still pills. This is because you are deficient in something. There is no way that you live on this earth, live in this environment and eat this food, and be completely healthy without taking pills.
Read MoreI want to remind you about dosing. In order to get any recipe right, my grandfather always said (my grandmother hated cooking) that he had to follow the amounts exactly for the end result to be perfect. Too much brandy in the stuffing was one thing, but not enough baking soda was deadly!
Read More